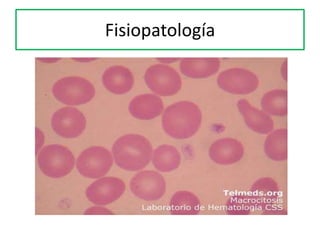
Fisiopatología

Incrustar presentación
Descargado 167 veces












































Este documento trata sobre las causas y manifestaciones de la anemia megaloblástica por deficiencia de ácido fólico y vitamina B12. Explica que la anemia megaloblástica puede deberse a una deficiencia nutricional, malabsorción, aumento de las necesidades o inhibidores del metabolismo de los folatos y la vitamina B12. Describe las funciones de estos nutrientes, los síntomas clínicos de la deficiencia y los métodos de diagnóstico y tratamiento como recuentos sanguíneos, nive